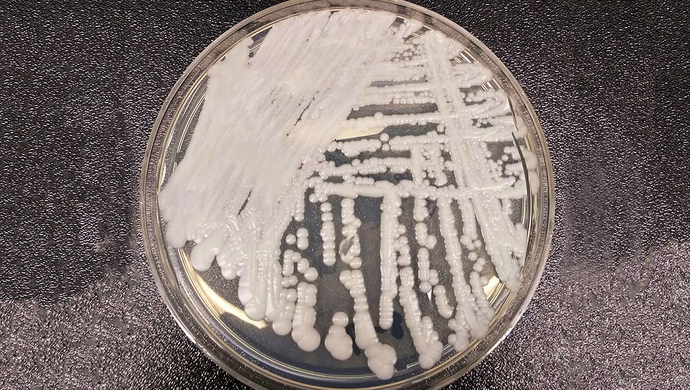

据《纽约时报》等多家媒体报道,一种名为耳念珠菌的多重耐药性真菌近日在美国多地爆发,目前美国已有587例确诊病例,遍布12个州。据悉,纽约市西奈山医院去年5月为一名老年男子做腹部手术时,发现他感染了一种“神秘而致命”的真菌,医院迅速将其隔离,但该男子最终在住院90天后死亡,可这种致命的真菌却顽强地存活下来。更为棘手的是,病房很多地方都遭到了入侵,院长Scott Lorin表示,为此院方对墙壁、病床、门、水槽、电话都进行了特殊消毒,甚至拆除了部分天花板和地板。
耳念珠菌致死率极高,近50%的感染者在90天内死亡,因此目前,美国疾病控制与预防中心已将其列入“紧急威胁”名单。而在中国,亦有相似感染病例:中国工程院院士、海军军医大学附属长征医院皮肤科教授廖万清表示,截至目前,中国已确认18例耳念珠菌临床感染病例,相关检测持续正在进行。“总体来看,我国还没有出现像美国那样的爆发性流行感染,市民无需过度恐慌。”
耳念珠菌是什么?
2009年,耳念珠菌在一名日本患者的外耳道分泌物中首次发现,它可以从皮肤、泌尿生殖道和呼吸道等分离出,从而导致侵袭性感染,如念珠菌菌血症、心包炎、泌尿道感染和肺炎等,大多数患者均会出现不明原因的高热,且伴有各种器官衰竭等,死亡率超过50%。
上海市微生物学会微生物耐药防控专委会主委、上海交通大学医学院附属瑞金医院感染预防管理科主任倪语星告诉解放日报·上观新闻记者,随着诊断检验技术的提高,原本不易识别的耳念珠菌正在逐步被医疗机构广泛认识,“它是一种超级真菌,使用传统的生化鉴定、显微镜观察等方法可能难以鉴定区分,目前主要使用的是质谱技术和分子生物学鉴定方法。”
耳念珠菌长啥样?它的来源目前尚不明确,在显微镜下,与其他念珠菌也并无明显差异,但性质却大大不同:“耳念珠菌具有多重耐药性,部分菌株甚至对目前临床常用的三大类抗真菌药物都有高耐药性。”倪语星表示,免疫力低下的人群最易感染,如体弱的老年人、新生儿、糖尿病患者、重症监护室患者及术后患者,“因此它最容易导致院内感染的爆发,且黏附能力很强,医疗机构与养老机构等应引起充分重视。”
据悉,2018年,中国发现首例耳念珠菌临床感染病例,该研究由北京大学医学部检验学系主任、北京大学人民医院检验科主任王辉与中科院微生物研究所真菌学国家重点实验室研究员黄广华团队共同完成。首株耳念珠菌来自一名76岁的患者,此后,中国医科大学附属第一医院、军事医学科学院等也分别先后检出过15例及2例,至此,我国大陆地区共确认18例耳念珠菌临床感染病例,廖万清透露,其所在的多个院士工作站都在进行相关监测,以防漏检导致耳念珠菌在国内流行爆发。
一个温度计引发的“血案”
针对大众关心的“是否会引起大规模流行爆发”问题,廖万清表示,根据目前监测结果来看,中国出现耳念珠菌爆发性流行的可能性较低,“但我们需要警惕超级真菌的潜在威胁,做到早发现、早隔离、早治疗。”
2018年,《新英格兰医学杂志》曾刊登一篇关于耳念珠菌的研究报道,在英国牛津大学附属医院神经科重症监护中心,作者发现耳念珠菌出现了感染爆发:2016年11月、2017年2月和2017年4月共采集的128份环境标本中,耳念珠菌在普通环境或空气中几乎未检出,但是,可以从患者的监测仪和升降机上检出该微生物,“这意味着,在ICU最为常见的医疗设备,如腋下体温探头和脉搏血氧仪等,都可能成为耳念珠菌生存的空间。”倪语星说,比起普通大众,聚集着免疫力低下人群的医疗机构理应绷紧院感预防管理这根弦,“尤其是对于器械的清洁,如呼吸机、血透留置导管等接口处,必须做好更为充分的消毒。”
对于普通健康人群而言,耳念珠菌并没有那么可怕,另外,耳念珠菌对于氟康唑、伏立康唑等广谱三唑类抗真菌药有较强耐药性,但棘白菌素类药物对于部分菌株尚有治疗效果,因此它并非完全“无药可治”。但倪语星也表示,做好手卫生、不滥用抗生素及抗真菌药物等是普通市民日常需注意的事项,“另外,若前往医院探视患者,应使用一次性手套、口罩、隔离衣等做好一定隔离防护,离开医院前应彻底洗手并用速干手消毒剂擦拭双手。”